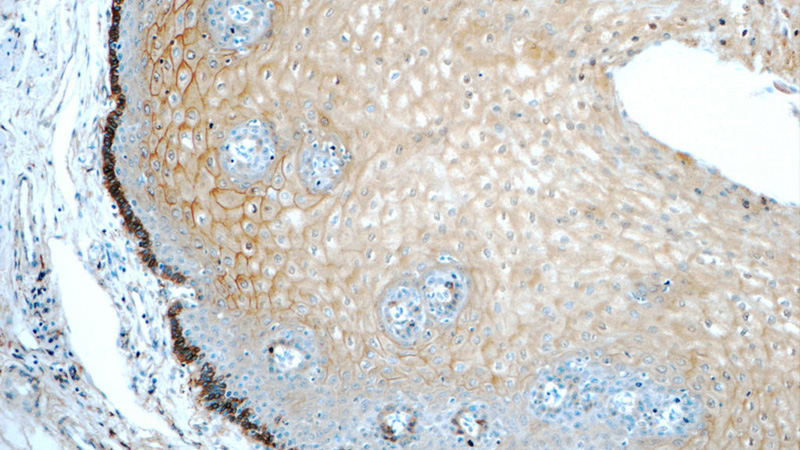
Immunohistochemistry of paraffin-embedded human oesophagus tissue slide using Catalog No:108089(ANXA1 Antibody) at dilution of 1:50 (under 10x lens)

-
Product Name
Annexin A1 antibody
- Documents
-
Description
Annexin A1 Rabbit Polyclonal antibody. Positive WB detected in K-562 cells, HeLa cells, HepG2 cells. Positive IHC detected in human oesophagus tissue, human colon tissue. Positive FC detected in HeLa cells. Observed molecular weight by Western-blot: 39 kDa
-
Tested applications
ELISA, WB, IHC, FC
-
Species reactivity
Human; other species not tested.
-
Alternative names
Annexin 1 antibody; annexin A1 antibody; Annexin I antibody; ANX1 antibody; ANXA1 antibody; Calpactin 2 antibody; Calpactin II antibody; Chromobindin 9 antibody; LipOCortin I antibody; LPC1 antibody; p35 antibody
-
Isotype
Rabbit IgG
-
Preparation
This antibody was obtained by immunization of Peptide (Accession Number: NM_000700). Purification method: Antigen affinity purified.
-
Clonality
Polyclonal
-
Formulation
PBS with 0.02% sodium azide and 50% glycerol pH 7.3.
-
Storage instructions
Store at -20℃. DO NOT ALIQUOT
-
Applications
Recommended Dilution:
WB: 1:200-1:1000
IHC: 1:20-1:200
-
Validations

K-562 cells were subjected to SDS PAGE followed by western blot with Catalog No:108089(ANXA1 antibody) at dilution of 1:300
Immunohistochemistry of paraffin-embedded human oesophagus tissue slide using Catalog No:108089(ANXA1 Antibody) at dilution of 1:50 (under 10x lens)

Immunohistochemistry of paraffin-embedded human oesophagus tissue slide using Catalog No:108089(ANXA1 Antibody) at dilution of 1:50 (under 40x lens)

1X10^6 HeLa cells were stained with 0.2ug ANXA1 antibody (Catalog No:108089, red) and control antibody (blue). Fixed with 90% MeOH blocked with 3% BSA (30 min). Alexa Fluor 488-congugated AffiniPure Goat Anti-Rabbit IgG(H+L) with dilution 1:1000.
-
Background
ANXA1, also named as ANX1, LPC1 and p35, belongs to the annexin family. It is a member of the annexin family of Ca2+-binding and phospholipidbinding proteins, and it is particularly abundant in various populations of peripheral blood leukocytes. ANXA1 regulates phospholipase A2 activity. It seems to bind from two to four calcium ions with high affinity. ANXA1 is a pleiotrophic protein produced by many cell types including peripheral blood leucocytes. The antibody is specific to ANXA1.
-
References
- Biaoxue R, Xiling J, Shuanying Y. Upregulation of Hsp90-beta and annexin A1 correlates with poor survival and lymphatic metastasis in lung cancer patients. Journal of experimental & clinical cancer research : CR. 31:70. 2012.
- Biaoxue R, Shuanying Y, Wei L, Zongjuan M, Xiguang C, Qiuhong Z. Co-overexpression of Hsp90-β and annexin A1 with a significantly positive correlation contributes to the diagnosis of lung cancer. Expert review of molecular diagnostics. 14(8):1067-79. 2014.
- Rong B, Zhao C, Liu H. Elevated serum annexin A1 as potential diagnostic marker for lung cancer: a retrospective case-control study. American journal of translational research. 6(5):558-69. 2014.
- Guo X, Hu H, Chen F. iTRAQ-based comparative proteomic analysis of Vero cells infected with virulent and CV777 vaccine strain-like strains of porcine epidemic diarrhea virus. Journal of proteomics. 130:65-75. 2016.
Related Products / Services
Please note: All products are "FOR RESEARCH USE ONLY AND ARE NOT INTENDED FOR DIAGNOSTIC OR THERAPEUTIC USE"
